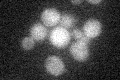
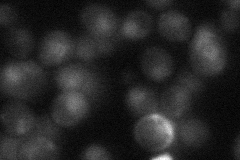
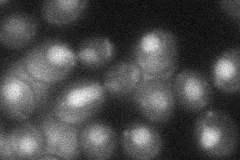

View description
Subunit of a replication-pausing checkpoint complex (Tof1p-Mrc1p-Csm3p) that acts at the stalled replication fork to promote sister chromatid cohesion after DNA damage, facilitating gap repair of damaged DNA; interacts with the MCM helicase
Localization:
Intensity:
Fold change:
Significance:
-
C’ GFP library in SD
below threshold17.08 -
N' NOP1pr-GFP in SD

nucleus57.7017 -
N' TEF2pr-mCherry in SD

nucleus101.304 -
N' NATIVEpr-GFP in SD
nucleus23.1848 -
N' TEF2pr-VC and Cyto-VN in SD
nucleus34.9203 -
C’ GFP library in SD+DTT

cytosol16.090.94No -
C’ GFP library in SD+H2O2

cytosol18.621.08No -
C’ GFP library in Starvation Media

cytosol15.90.93No -
C’ GFP library on the background of Pup2-DaMP

below threshold -
C’ GFP library on the background of CCT mutant

below threshold17.77281.04011No
